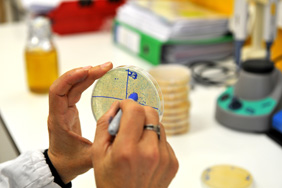
image description
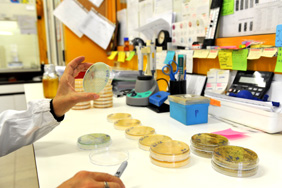
image description

Gli operatori del settore alimentare sono tenuti a rispettare i criteri microbiologici, che devono essere applicati per la validazione e la verifica delle procedure HACCP (Hazard Analysis Critical Control Point ovvero analisi dei pericoli e controllo punti critici).
A questo scopo il nostro laboratorio collabora con le aziende per l'esecuzione delle analisi in autocontrollo ponendosi come obiettivo primario la sicurezza e la salubritá dei prodotti alimentari garantendo l'igiene dell'intero ciclo produttivo (dalla materia prima al prodotto finito).
Il Laboratorio di microbiologia de LA.ECO.VET. dispone delle attrezzature e delle metodiche analitiche per eseguire:
-
Analisi microbiologiche standard su materie prime, semilavorati e prodotti finiti
- Carica microbica a 30°C
- Anaerobi solfito riduttori
- Bacillus cereus
- Campylobacter spp
- Coliformi fecali
- Coliformi totali
- Clostridium perfrigens
- Clostridium botulinum
- Enterobatteri
- Escherichia coli
- E.coli 0157:H7
- Enterococchi
- Yersinia enterocolitica
- Lattobacilli
- Muffe e Lieviti
- Listeria monocytogenes qualitativa e quantitativa
- Microrganismi mesofili aerobi e anaerobi
- Microrganismi sporigeni aerobi e anaerobi
- Microrganismi psicrotrofi
- Pseudomonas spp
- Stafilococco aureo
- Stafilococco coagulasi positivo
- Streptococchi fecali
- Enterotossine stafilococciche
- Shigella spp
- Salmonella spp.
- Tipizzazioni come da nuovo Reg. n.1086/2011: Salmonella enteritidis e thiphymurium
- etc…
-
Campionamento microbiologico negli stabilimenti di macellazione (spugne sulle superfici delle carcasse animali secondo Reg. CE 2073/2005 e s.m.i.) per la ricerca di:
- Carica microbica a 30°C
- Enterobatteriacee
- Salmonella
- Analisi con metodiche valide per l'esportazione dei prodotti alimentari in Stati Uniti, Russia e Giappone.
- Ricerca di sostanze inibenti (Car test)
-
Analisi delle acque destinate al consumo umano secondo il D.Lgs.31/2001
- Conteggio delle colonie a 22°C
- Conteggio delle colonie a 37°C
- Escherichia coli
- Enterococchi intestinali
- Batteri coliformi
- Clostridium perfringens (spore comprese)
- Stafilococchi patogeni
- Pseudomonas aeruginosa
- etc…
-
Ricerca e identificazione di Legionella spp. e pneumophila sulle reti idriche
L'habitat delle legionelle é costituito da diversi ambienti acquatici naturali o artificiali e da terreni umidi: esse possono entrare nei sistemi idrici in basse concentrazioni e trovarvi poi condizioni favorevoli allo sviluppo (temperature idonee tra 25° e 42 °C, presenza di biofilm, amebe, ristagni, sedimenti e incrostazioni calcaree, specie nei rami morti, materiali favorenti quali silicone, gomma ecc…). Le legionelle possono svilupparsi in impianti che fanno parte del nostro ambiente quotidiano: reti collettive di distribuzione di acqua calda (rubinetti e docce), vasche di idromassaggio, serbatoi, circuiti di raffreddamento ad acqua e torri di raffreddamento associate ai sistemi di climatizzazione, umidificatori adiabatici e ad acqua, circuiti dei riuniti odontoiatrici, fontane ornamentali e macchine per la preparazione del ghiaccio. Le strutture ricettive e sanitarie devono provvedere quindi alla valutazione del rischio ed all'analisi a titolo preventivo
Il campionamento ai punti terminali della rete idrica puó essere eseguito con due modalitá:
Pre-flushing
Valuta il rischio reale per l'utente all'apertura del rubinetto nelle normali condizioni di utilizzo dell'acqua
Post-flushing
Valuta l'efficacia dei metodi di bonifica adottati e calcola la carica totale del sistema idrico, prelevando il campione dopo aver fatto scorrere l'acqua fino alla stabilizzazione della te -
Analisi microbiologiche delle acque di piscina secondo l'accordo 16 gennaio 2003 “Conferenza permanente per i rapporti tra Stato, Regione Province autonome” che determina i requisiti dell'acqua in immissione ed in vasca:- Carica Batterica a 22°C
- Carica Batterica a 36°C
- Escherichia coli
- Enterococchi
- Stafilococcus aureus
- Pseudomonas aeruginosa
-
 Monitoraggio ambientale (attrezzature e superfici sanificate ed in corso di lavorazione) per la ricerca dei microrganismi indicatori di contaminazione e patogeni
Monitoraggio ambientale (attrezzature e superfici sanificate ed in corso di lavorazione) per la ricerca dei microrganismi indicatori di contaminazione e patogeni
- Carica microbica a 30°C
- Coliformi termo tolleranti
- Coliformi totali
- Enterobatteriacee
- Escherichia coli B-glucoronidasi positivo
- Lieviti e muffe
- Stafilococco coagulasi positivo (stafilococco aureo e altre specie)
- Bacillus cereus
- Listeria monocytogenes
- Salmonella spp
- Etc…
-
Analisi di acque e fanghi di depurazione agroindustriali e civili
- Salmonelle
- Coliformi fecali
- Coliformi totali
- Streptococchi fecali
- Etc…
-
Analisi di cosmetici
- Batteri mesofili aerobi
- Muffe e lieviti
- Escherichia coli
- Pseudomonas aeruginosa
- Staphylococcus aureus
- Challenge test
- Etc…
-
 Prove di Shelf-Life:
Prove di Shelf-Life:
La qualitá di un prodotto puó essere valutata con prove sensoriali, organolettiche, e microbiologiche. La shelf-life definisce, attraverso quest'insieme di prove, la durabilitá del prodotto, vale a dire il tempo limite entro il quale l'alimento conserva le sue proprietá specifiche ed é ancora accettabile ed adatto al consumo sul piano della sicurezza. Gli studi di shelf-life permettono quindi di determinare in quanto tempo avvengono le alterazioni microbiologiche, fisiche ed organolettiche nell'alimento durante tutte le fasi della sua vita commerciale. Il laboratorio di microbiologia de LA.ECO.VET. é in grado di effettuare sugli alimenti prove di shelf-life che comprendono analisi all'inizio della produzione, a step intermedi a seconda del periodo di conservabilitá ed alla scadenza dei prodotti stessi.
-
Esami Microscopici
- Filth-test su farine, cereali, riso, grano, mais e derivati, paste alimentari.
Il Filth test permette di verificare l'eventuale inquinamento da corpi estranei solidi, in modo particolare di origine biologica, e di identificarne la tipologia (frammenti di insetti, peli di mammiferi, larve, ecc…). - Ricerca di farine di origine animale in alimenti zootecnici.
- Ricerca di Anisakis: nei prodotti ittici freschi é possibile la presenza di questi parassiti; l'operatore del settore alimentare che produce, commercializza o prepara pesce o prodotti a base di pesce é il primo responsabile della sicurezza sanitaria degli alimenti immessi sul mercato, per cui questo pericolo deve essere preso in considerazione nei manuali e nei campionamenti in autocontrollo.
- Filth-test su farine, cereali, riso, grano, mais e derivati, paste alimentari.